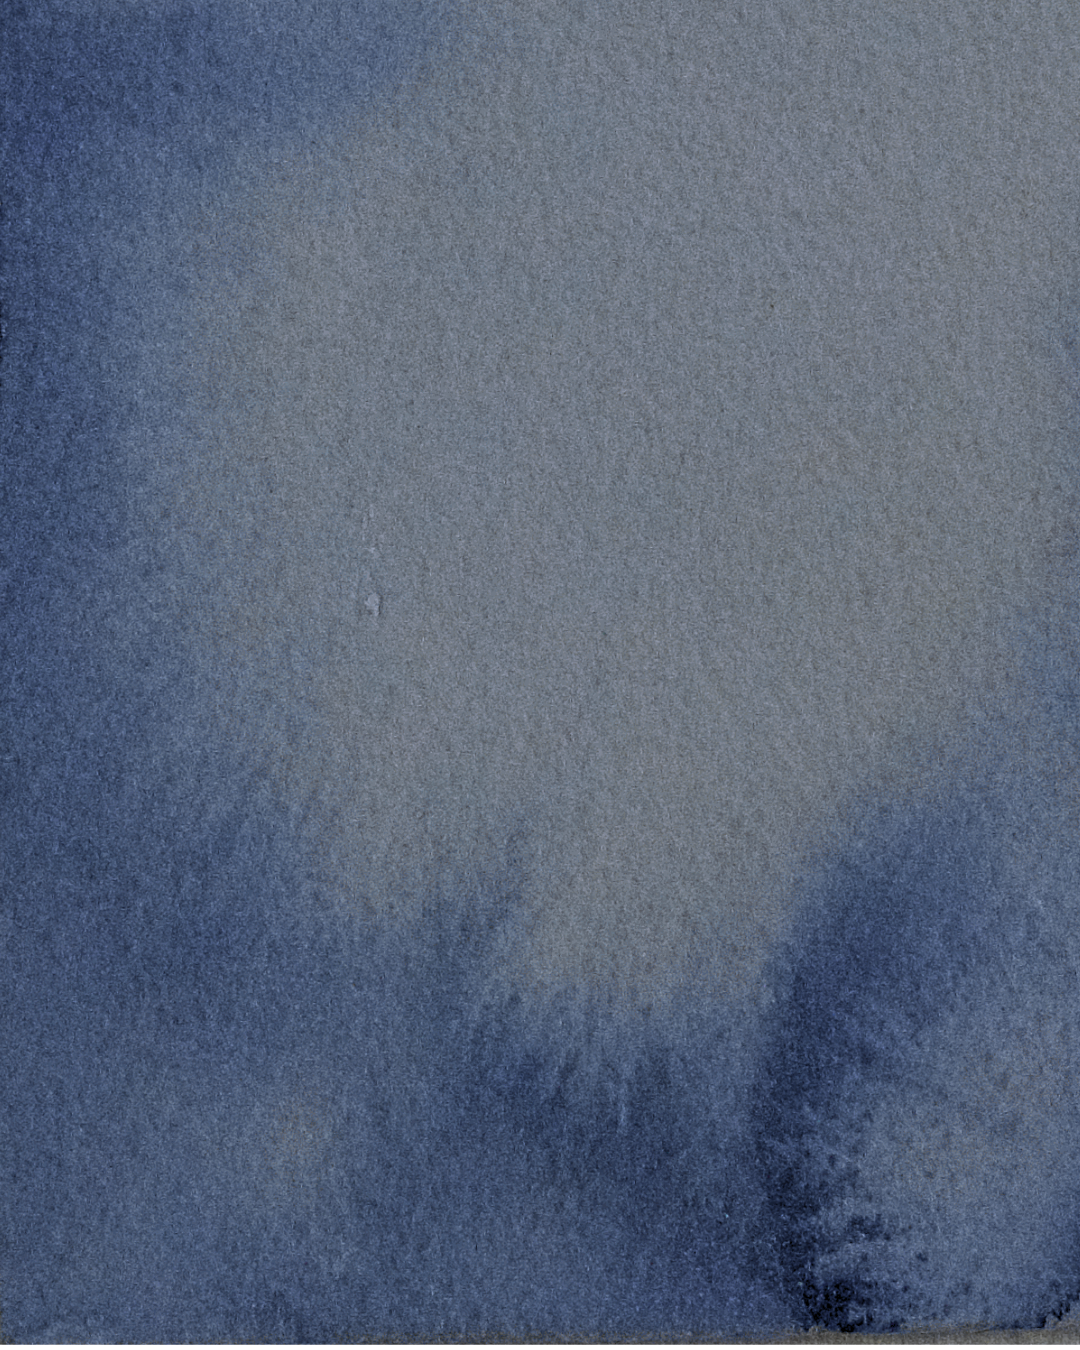

This watercolor series is a bold exploration of color, texture, and intuitive expression. With a focus on artistic identity, each piece reflects a refined, personal visual language. The work invites viewers to connect with the raw, experimental side of my process.

Natural Order

Tideform

Stillcurrent

Starbind

Greenburst

Veilgreen

Burnstar

Lightscatter

Glowfront

Spiralroot

Stardrift

Pulsegrid

Touchspiral

Saltform

Liftline

Bloommark

Orbitleaf

Foilveil

Impression

Spokeshift

Edgeglow

Gluescape

Petaltrace

Vinedrift

Swirlwire

Coincircle
Pulse

Trace

Vein

Drift
